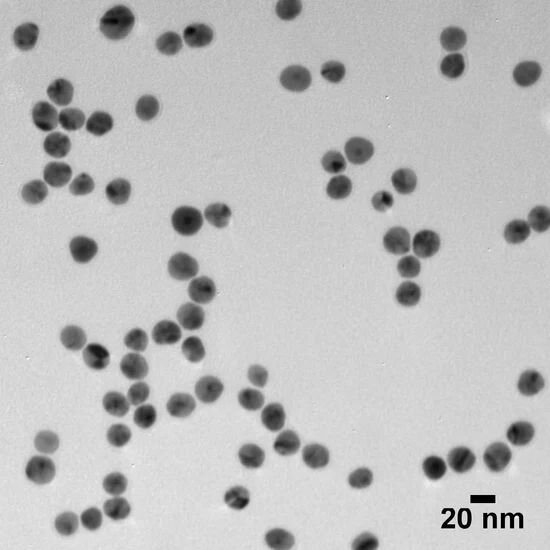
Silver Shelled Gold Nanospheres

Silver Nanoparticles
Silver nanoparticles combine strong optical properties with antimicrobial capabilities. These nanoparticles are used in a variety of applications including diagnostics, nanomedicine, biosensors, and optical engineering. We provide high-purity, monodisperse, silver nanoparticles in varying sizes, shapes and surface modifications.
All our products are supplied with a batch-specific Certificate of Analysis including characterization data such as TEM, DLS, Zeta, and UV-Vis, as appropriate to the material.
Contact us for custom formulations, cGMP manufacturing in our ISO 13485 certified facility or request a quote for bulk suppy.

Why Purchase From Us?
Aggregation-free nanoparticles. Successful processes start with quality reagents – our processes allow us to provide high-quality, monodisperse nanoparticles.
Extensive characterization data. Experience the peace of mind of knowing exactly what you are purchasing for your application.
Exceptional customer service. Whether you need help with your order or integrating our particles into your application, our experts are here to help solve any issues in a professional and timely manner.
Our Silver Nanoparticle Products